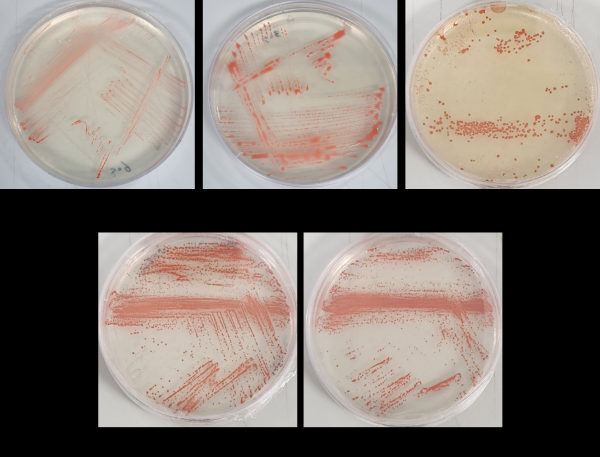

[충청25시] 환경부 소속 국립생물자원관은 최근 인천의 염전에서 채취한 시료의 미생물 유전체를 분석해 전량 수입 중인 피부를 보호하는 붉은색 유기 색소 생산 유전자 및 신경세포 흥분 억제와 관련된 유전자를 발견했다고 밝혔다.
국립생물자원관과 인천대학교 서명지 교수 연구진은 올해 추진한 ‘자생생물의 환경 적응 및 진화 유전자 연구 사업’ 과정에서 호염성 고균의 유전체를 분석해 박테리오루베린을 생산하는 11종의 고균을 확인했다.
붉은색 유기 색소인 박테리오루베린은 자외선과 외부 환경으로부터 호염성 고균을 보호하는 강한 항산화 효과를 가지고 있는 것으로 알려져 면역강화, 노화방지, 피부 건강 유지와 같은 다양한 분야에서 기능성 소재로써 활용이 가능하다.
아울러 이번 연구에서 확인된 11종 중에서 5종의 호염성 고균은 빛을 이용해 신경세포의 활성을 제어할 수 있는 유전자도 보유한 것으로 확인됐다.
이 유전자는 광유전학적 도구로 활용 가능한 단백질인 할로로돕신 생산에 관여한다.
해외에서는 박테리오루베린 추출물을 원료로 하는 고급 항노화 피부관리 제품 등이 시판 중이며 할로로돕신이 쥐의 흥분을 장시간 억제하는 것을 확인해 신경세포 안정에 적용하기 위한 연구도 진행되고 있다.
국립생물자원관은 이번에 발견한 11종의 호염성 고균을 내년 상반기 국제학술지에 투고하고 기능성 소재로 상용화된 해외 미생물을 대체하기 위한 후속 연구를 진행할 예정이다.
서민환 국립생물자원관장은 “자생 미생물을 발굴해 유전체로부터 유용한 자원을 확보하고 이를 활용하기 위한 연구도 지속적으로 추진할 계획이다”고 밝혔다.
저작권자 © 충청25시 무단전재 및 재배포 금지

